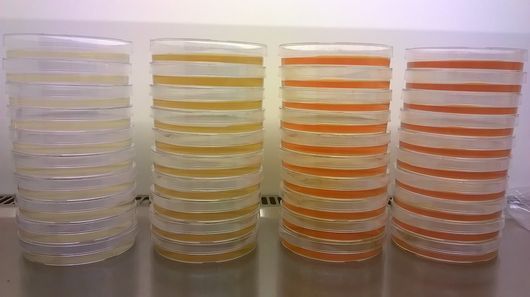

Molecular Plant Biophysics and Biochemistry

Plant Biophysics and Biochemistry Labs

Saint Antonius, the patron of all omics research, helps looking for the needle in the haystack
Electrophysiology lab

Set-ups for turgor pressure measurements and electrophysiology work
Biochemistry lab

Fill me!

… lots of space, light and green
Plant Molecular Biology/Biotechnology lab

RT-PCR, SOE-PCR, RACE-PCR and RIP-PCR
… Forty shades of Yellow